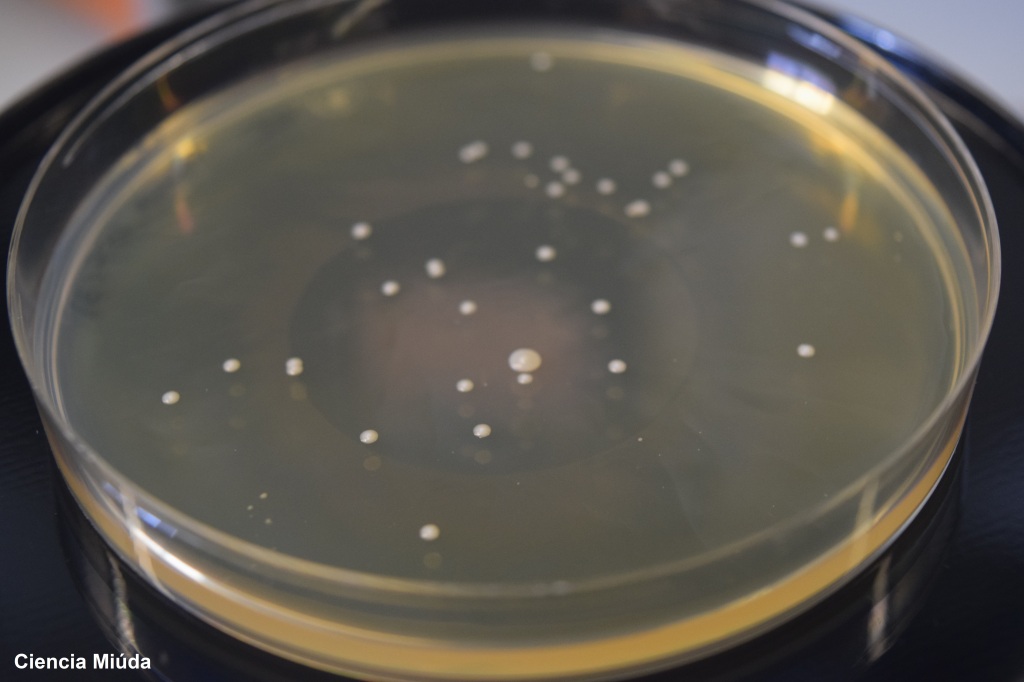

Llega fin de año y yo, como cada año, me pongo nostálgica. Como este es un blog de divulgación científica creo que pocas formas hay mejores para despedir el año que hacer un repaso de las 10 entradas que más habéis visitado durante 2021. Os reconozco que hay varias de ellas que me sorprenden bastante, ya que no se encuentran entre mis favoritas. Pero bueno, los que mandáis sois vosotros así que aquí tenéis la lista:
1.La física en la ley de Murphy. Uno de mis artículos de divulgación favoritos. Y es que quién no se ha preguntado nunca por qué la tostada siempre cae por el lado de la mantequilla.

2.¿Se puede pensar sin un lenguaje? Este es uno de los que más me ha costado escribir (tenía que hacerlo como tare en el máster de cultura científica). La verdad es que hasta que lo pensé nunca me había dando cuenta de somos capaces de pensar un lenguaje que nos permite articular nuestros pensamientos.

3. El sistema solar a escala. Que algo sea grande o pequeño siempre es bastante relativo, y es que dependo mucho de con que lo compares. Aquí os traigo mi versión casera del sistema solar.

4. La física de las bacterias. Mi primer artículo de divulgación escrito para este blog. Quizá un poco breve. Pero según dicen por ahí si lo bueno es breve, dos veces bueno.
5. Elementos gráficos en publicaciones científicas. Lo sé, no me esmeré mucho con el título pero parece que el contenido os gusto bastante. Y es que aunque a los que trabajamos en ciencia estas cosas nos parecen bastante simples al resto de la gente le genera curiosidad y le gusta saber sobre estas cosas.

6. La física de las galletas. Uno de mis artículos de divulgación favoritos. ¿Sabes por qué las galletas se rompen cuando las mojamos en la leche?

7. La Conferencia Solvay de 1927, una reunión de genios. Uno de los congresos más famosos del mundo. En su icónica foto salen 28 personas y Marie Skłodowska-Curie, de ellos 17 ya habían ganado o ganarían un Premio Nobel.

8. ¿Puede la tecnología ser buena o mala? Solemos pensar en la tecnología como algo neutral pero…¿y si ya esta diseñada para encarnar ciertas formas de poder y autoridad específicas? ¿y si una tecnología “solucionadora” está generando las condiciones para provocar problemas más graves en el futuro?

9. Arte, lenguaje y comunicación. ¿Puede el arte no comunicar nada?

10. Algoritmo A*. Un algoritmo que se usa para buscar la mejor ruta posible y eficiente (menos coste) entre dos puntos.

¿Qué os ha parecido la lista?¿Echáis de menos algún artículos que os haya gustado y que no está aquí?
Que tengáis un buen fin de año 2021, y un 2022 que seguro que, al menos, vendrá cargadito de divulgación para mentes curiosas.
